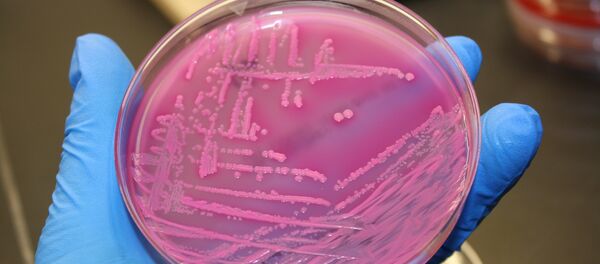
E. coli bacteria E. coli bacteria - Sputnik International

The team is led by Han Chunyu, a biologist from North China's Hebei Province. The thesis was retracted "because of the continued inability of the research community to replicate the key results in Figure 4, using the protocols provided in our paper," read a retraction notice by Han's team published on the journal's website Wednesday.
The team is retracting their initial report at this time "to maintain the integrity of the scientific record," the notice said.
Han, an associate professor at the College of Bioscience & Bioengineering of Hebei University of Science and Technology (HUST), announced that he and his team had discovered how to use the bacterial enzyme NgAgo to replicate and edit DNA, and published the findings in the journal on May 2, 2016.
Han's discovery was hailed in China after the findings' publication, which some media said was worthy of a Nobel Prize.
However, an increasing number of Chinese and foreign biologists said they could not replicate the findings. Among them were Gaetan Burgio, head of the transgenesis lab at the Australian National University, who rescinded his previous statement that using NgAgo to edit gene fragments in mice was efficient.
Han's team released a notice Thursday, saying that they are voluntarily retracting the paper and will follow the university's arrangements and choose a third-party laboratory to conduct their experiments with the help of peer experts.
"We have found in recent experiments that the successful importing of ssDNA guide into the cell to combine with NgAgo is the key to effective NgAgo gene-editing," the notice said.
HUST said on its website Thursday that the university will launch an academic appraisal of Han's study.
This article was originally published by the Global Times.